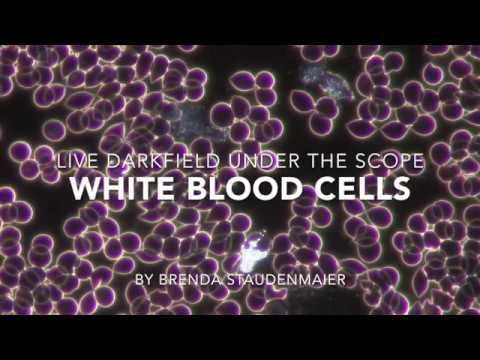
featured

The Lovely Brenda (29)
249 followers26 posts4 following7 HP
Blacklisted UsersMuted UsersFollowed BlacklistsFollowed Muted Lists
Blacklisted UsersMuted UsersFollowed BlacklistsFollowed Muted Lists
Green Bay, WI Joined August 2016 Active 6 years ago